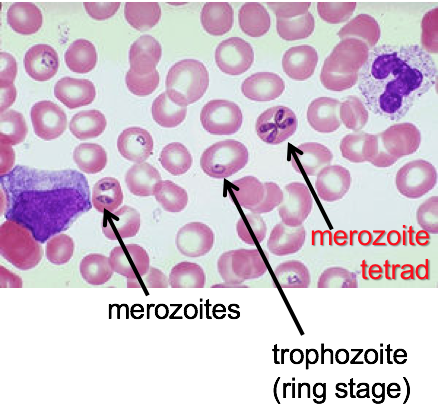

Ehrlichia chareensis infects ____ and causes a disease called _______
Ehrlichia chareensis infects monocytes and causes a disease called Human Monocytic Ehrlichiosis (HME)
Anaplasma phagocytophilum infects _____ and causes a disease called _____
Anaplasma phagocytophilum infects granulocytes (specifically neutrophils) and causes a disease called Human granulocytic anaplasmosis (HGA)
Malaria specied infect ____ cells and ____ cells
red blood cells and liver cells
Babesia microti infects ____ cells
red blood cells
Trypanosoma species infects ____ and _____
monocytes and macrophages
Leishmania species infect _____ and _____
macrophages and reticuloendothelial cells
Describe the characteristics of Ehrliciha:
obligate intracellular gram-negative bacteria
tick borne
Describe the characteristics of Anaplasma:
obligate intracellular gram-negative bacteria
tick borne
Where/when are cases of Ehrlichia most common?
Southeast to south central US
Most cases occur in the spring and summer
How is Ehrlichiosis transmitted?
Vector:
Animal reservoir:
Other routes:
Morulae:
Seen in monocytes with Ehrlichiosis infection and granulocytes with Anaplasmosis infection.
Vacuoles containing bacteria in infected cells.
How is Ehrlichoisis diagnosed?
Indirect fluorescent antibody (IFA) - Acute and convalescent serology
Examination of peripheral blood
PCR
Immunochemical staining in tissue
Clinical diagnosis
When/where are cases of Anaplasmosis most common?
Upper midwest and northeast US (some in Europe)
Spring/summer
[high seroprevalence, so likely lots of asymptomatic transmission]
How is anaplasmosis transmitted?
Vector:
Animal reservoir:
Other routes:
How is anaplasmosis diagnosed?
Smear (Detects morulae in 20-75% of cases)
PCR
Serology
Clinical diagnosis
Compare/contrast clinical signs and symptoms of Ehrlichosis and Anaplasmosis
Incubation period 1-2 weeks after bite of infected tick
May cause asymptomatic to chronic infection
Typically an acute febrile illness (most cases). Infections more severe in immunocompromised
Rash and GI symptoms more common in Ehrlichosis

____% of confirmed cases of Ehrlichiosis are hospitalized. Explain.
62% of confirmed cases are hospitalized
Delay in antibiotic therapy is associated with an increased risk of mechanical ventilation and prolonged hospital stay.
Estimated mortality rate 2-5% (likely over estimated)
Multiorgan involvement in fatal cases with most bacteria in spleen, LN and BM
What is the appropriate treatment for Ehrlichiosis and Anaplasmosis?
Doxycycline (or tetracycline) because it can get into the cells
Trophozoites:
Form of parasite that is motile, feeding, reproducing
-mastigotes:
Flagellated form/stage of parasite
Sexual stages of parasites:
merozoites, schizonts, gametes, oocysts
What disease is suggested by this peripheral blood smear?

Babesiosis (Babesia microti)
Characteristic tetrad and ring stage
How is Babesia transmitted?
Vector:
Animal reservoir:
Other routes:
Where is Babesia most common?
Northeast and upper midwest